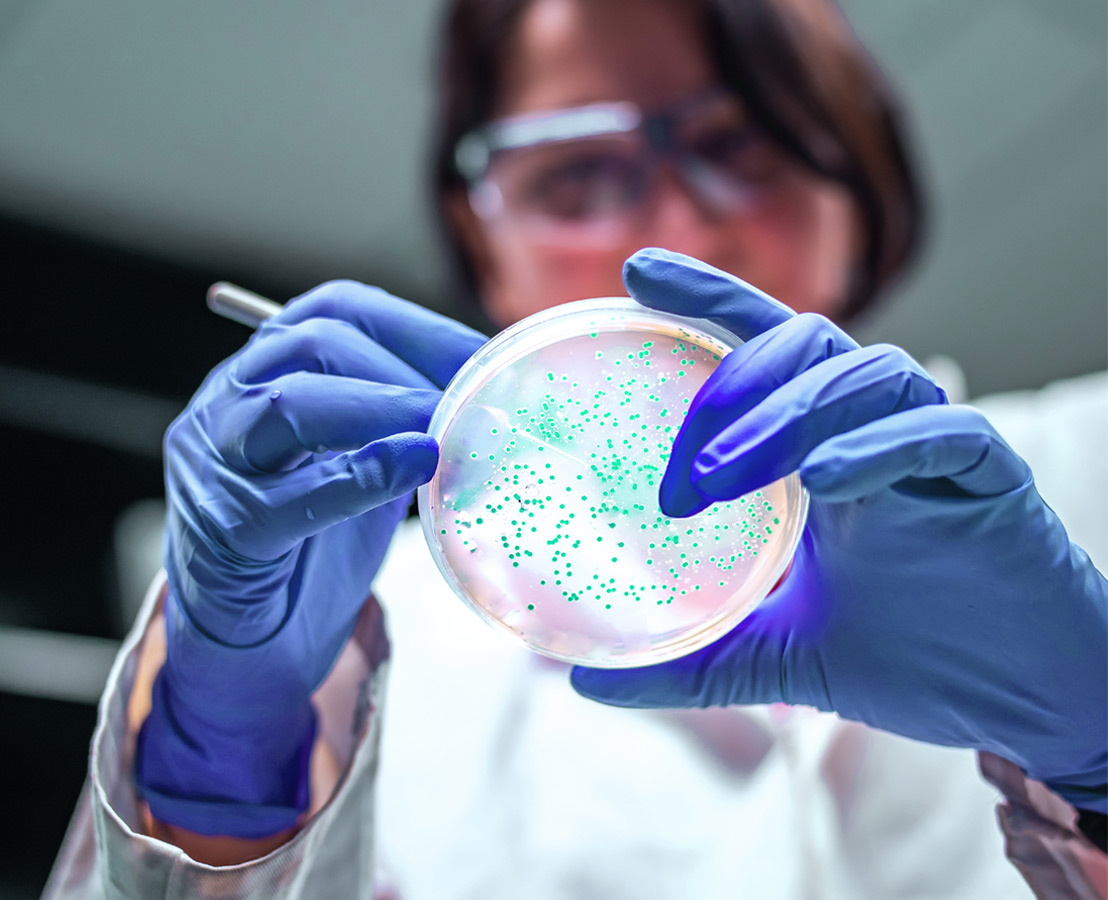

The birth of Viatris
In July 2019, the creation of a new company named Viatris was announced globally.
- Viatris provides a wide range of medicines, including branded drugs, generics
- Viatris has several manufacturing facilities in India that produce oral solid doses and injectables for a wide range of therapeutic areas
- Viatris’ commercial business in India, under Mylan Pharmaceuticals Private Limited, offers a large portfolio of products for therapeutic areas such as Infectious Diseases, Gastro & Transplant Care, Oncology, Non-communicable Diseases and Dermatology
- India is home to global R&D centers of excellence - one is based in Hyderabad, where a team of highly qualified scientists and regulatory affairs professionals research APIs, OSDs, and biologics, while another centre located in Bangalore focuses solely on injectables
- Our strength comes from approximately 9,000 employees from various parts of India, providing us with a diverse mix of individuals committed to delivering on our mission to help people in living healthier lives